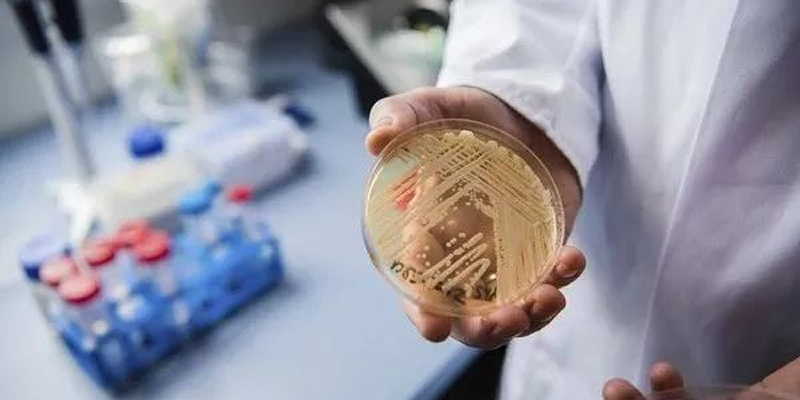

February 10, 2023
Cargill's world mycotoxin report provides actionable insights to improve livestock health
Cargill has announced the release of its 2022 World Mycotoxin Report, described as the most comprehensive data set on the regional prevalence of contaminants in common ingredients (like corn, cereal and oil seeds) used in animal feed, and their risks to bovine, poultry and swine.
The report contains more than 300,0000 mycotoxin analyses taken from 150 feed plants, on-farm samplings and storage locations, and provides info on the most problematic mycotoxins with their level of contamination and performance risk rates, and species sensitivity when exposed to a given mycotoxin.
"Our aim is to make the most comprehensive and trusted information available on mycotoxin risk to help livestock farmers protect the health of their animals and operations," said Gilles Houdart, global additive category director for Cargill's animal nutrition business. "With the Cargill World Mycotoxin Report, farmers and feed producers can directly benefit from Cargill's unique global footprint of animal nutrition expertise."
Despite the lack of visible symptoms, mycotoxins can wreak havoc on animal health and performance under the surface. Mycotoxins may, for instance, weaken the immune system and degrade nutrient absorption and vaccine response. If symptoms appear from mycotoxin exposure, it's an indication that the animal has been exposed to high levels of mycotoxins for a long time, and the producer faces costly measures to reverse the impact.
Global trends stated in the report are as follow:
- Contamination is the rule: In 2022, 75% of the 300,000-plus mycotoxin analyses conducted were positive and above detection limits. Also, the more tests are being conducted for mycotoxins, the more they will be found. For example, of samples tested for six mycotoxins, 84% were positive for four or more mycotoxins;
- Performance risk rates increased: Beyond the number of positive samples, it is important to consider contamination levels that may create a risk of reduced performance. For example, in 2022, 39% of analyses were above performance risk threshold, representing a 4% increase from 2021;
- Mycotoxins to watch: Fumonisin (FUM), vomitoxin (DON) and zearalenone (ZEN) remain the top three mycotoxins of concern. Over the past year, ZEN analyses above performance risk increased to 51% while FUM and DON remained elevated at 40% and 62%, respectively.
Ingredient trends stated in the report are as follow:
- Corn: 75% of corn-based ingredients (including all by-products) analyses were positive for at least one mycotoxin, and 39% were above performance risk thresholds. DON (63%), ZEN (55%), FUM (44%) and T2 (33%) were most frequently above performance risk levels in corn group analyses;
- Cereals: 81% of cereal-based ingredients analysed were positive for at least one mycotoxin, and 44% were above performance risk thresholds. In 2022, DON (66%), ZEN (31%), T2 toxin (T2, 28%), and aflatoxin (AFL) (25%) were most frequently above performance risk levels in cereal group analyses;
- Oilseeds: 64% of oilseeds-based ingredients analyses were positive for at least one mycotoxin, and 22% were above performance risk thresholds. ZEN (64%), T2 (24%) and AFL (15%) were most frequently positive amongst analyses and presented the highest over performance risk thresholds. Oilseeds had the lowest contamination concern.
Regional trends stated in the report are as follow:
- Regions with the highest mycotoxin prevalence and risk levels include China, Asia, North America and Europe. Conversely, the Middle East and Africa (MEA), Central and South America, and Russia show lower risk, though Russia (+11%) and MEA (+9%) have increased overall risk rates;
- Asia: AFL remained the highest risk in cereals and FUM in corn-based ingredients;
- Central and South America: Mycotoxins from fusarium moulds (ZEN, FUM, DON) represented significant risks for corn and cereals-based ingredients;
- China: Main concern was DON, ZEN and FUM in corn; DON and ZEN in cereals and ZEN in oilseeds;
- North America: DON remained a concern in corn and ZEN levels increased, particularly in the Northeast corn belt. FUM levels remained high in the Southern corn belt;
- Europe: DON still represented a high risk in cereals and corn-based ingredients. ZEN risk also increased in oilseeds;
- MEA: Increased overall risk with a 9% jump in the region from 2021. Substantial increases in ZEN, T2, FUM and DON, to a lower extent, particularly in corn;
- Russia: The country remains the region with the lowest mycotoxin rate; however, in 2022, it was observed that there was an 11% increase from 2021. T2, DON and ZEN contamination rates all doubled;
Species trends stated in the report are as follow:
- Bovine: DON and ZEN are most important to watch out for performance consideration in all regions. AFL is also a critical one, particularly in Asia, for dairy, calf and heifer;
- Poultry: FUM and ZEN are the two big culprits in most regions. Other culprits are DON (China, America and Europe), T2 (MEA, Europe, NA and Russia) and AFL (mainly Asia). It's important to consider ZEN as impacting all subspecies (and not only breeders or layers) and DON, which can impair growth performance even with a few hundred ppb;
- Swine: DON and FUM are the two big problems in most regions. Other culprits are AFL in Asia and T2 in Russia and Africa. ZEN impacts reproduction parameters for sow and can lower growth performance for all species with severe effects when combined with other mycotoxins.
In addition to the risk management data provided in the report, Cargill seeks to address the right approach to manage mycotoxins for operations. The organisation had developed the Mycotoxin Impact Calculator (MIC) to address this matter. The in-house tool is the latest in Cargill's toolbox to help the company and customers to identify and mitigate mycotoxins with data-backed insights in order to maximise performance and outcomes for animals and producers' bottom line.
"Our customers need real-time actionable data to help them make sound decisions for their business," said the author of the report, Clement Soulet, global additive category manager for Cargill's animal nutrition business. "Thanks to our data centralisation efforts and decision-making tools, Cargill helps to characterise mycotoxin risk for each situation to adopt the appropriate solution."
- Cargill










